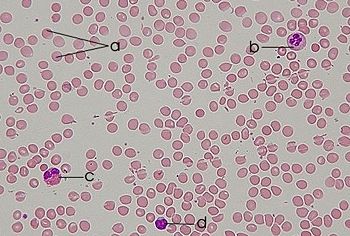

Blood
Blood is a highly specialized, circulating tissue that consists of several types of cells suspended in a fluid medium. Along with the heart (a pump) and blood vessels (a series of conduits), blood forms an essential part of the circulatory system, a system of gas exchange in all terrestrial vertebrates.
There are two main components of blood: Blood cells (collectively known as the hematocrit) and an aqueous medium for transporting the cellular materials (called the plasma). The hematocrit consists of three types of cells responsible for the blood's crucial functions:
- Red blood cells (erythrocytes) transport respiratory gases. Erythrocytes give vertebrate blood its distinctive color due to the presence of hemoglobin, an iron-containing protein that binds oxygen in the lungs and transports it to tissues in the body.
- White blood cells (leukocytes) serve an immunological function, defending the body against foreign materials.
- Platelets (thrombocytes) are cell fragments that play an important part in the clotting of the blood.
In addition to the roles outlined above, blood performs a range of functions, supplying nutrients such as glucose, amino acids, and fatty acids to various tissues; removing waste products such as carbon dioxide, urea, and lactic acid; transporting hormones and signaling tissue damage; and regulating the body pH and core body temperature required for a stable internal environment (homeostasis).
The term "blood" may also refer to a related circulatory fluid in certain invertebrates, such as arthropods and most mollusks, which is also known as the hemolymph. In these animals, there is no distinction between blood and interstitial fluid (the solution that bathes and surrounds the cells of multicellular animals).
Given its importance to life, blood has come to be associated with a number of cultural beliefs and practices. Blood continues to function as a symbol of family relationships: For example, to be "related by blood" is to be related by ancestry rather than by marriage. In both Islamic and Jewish dietary laws (Kashrut), consumption of food containing blood is forbidden. In certain Aboriginal Australian traditions, the ritual use of blood as adornment helps to attune the dancers to the invisible energetic realm of the Dreamtime (Lawlor 1991). Among certain Germanic tribes (such as the Anglo-Saxons and the Norsemen), blood was ritually sprinkled after battle (Blóts), as it was considered to retain the power of its originator. The vampiric folklore of Eastern Europe, in which the undead derive sustenance from the blood of living beings, attests to the mythological power of blood as well as to fears about contamination through blood.
Components and properties
Blood contributes about 7 percdent of the human body weight (Alberts 2005), with an average density of approximately 1060 kg/m³ (Shmukler 2004). The average adult has a blood volume of roughly 5 liters. Blood cells constitute about 45 percent of whole blood by volume, with the other 55 percent represented by plasma, a fluid that is the blood cells' liquid medium, appearing golden-yellow in color.
Types of blood cells
Each liter of human blood contains the following cellular components:
- 5 × 1012 erythrocytes (45.0 percent of blood volume): Red blood cells (erythrocytes) are shaped like discs, giving them a large surface for gas exchange; their flexibility also enables them to squeeze through capillaries. In mammals, mature red blood cells lack a nucleus and organelles. They contain the blood's hemoglobin and distribute oxygen. The red blood cells (together with endothelial vessel cells and some other cells) are also marked by glycoproteins that define the different blood types (see below). The combined surface area of all the red blood cells in the human body would be roughly 2,000 times as great as the body's exterior surface.
- 9 × 109 leukocytes (1.0 percent of blood volume): White blood cells are part of the immune system; they destroy and remove old or aberrant cells and cellular debris as well as attack infectious agents (pathogens) and foreign substances.
- 3 × 1011 thrombocytes (<1.0 percent of blood volume): Platelets are responsible for blood clotting (coagulation). They are activated when they come into contact with exposed collagen fibers, and work in tandem with components in the blood plasma, called blood clotting factors.
Blood plasma
Blood plasma is essentially an aqueous solution containing 92 percent water, 8 percent blood plasma proteins, and trace amounts of other materials. It includes a variety of components, from gases and ions (mostly sodium and chloride ions, which give blood its salty taste) to nutrients, hormones, and immunoglobulins (antibodies). The most abundant blood plasma protein in humans and other mammals is serum albumin, which is essential for maintaining the osmotic pressure needed for proper distribution of body fluids.
Properties of blood vary by species
The normal pH of human arterial blood is approximately 7.40, a weak alkaline solution. Blood that has a pH below 7.35 is considered overly acidic, while blood pH above 7.45 is too alkaline. Blood pH, along with arterial carbon dioxide tension (PaCO2) and HCO3 readings, is helpful in determining the acid-base balance of the body. The respiratory system and urinary system normally control the acid-base balance of blood as part of homeostasis.
In humans and other hemoglobin-using creatures, oxygenated blood is bright red, due to the oxygenated iron-containing hemoglobin found in red blood cells. Deoxygenated blood is a darker shade of red, which can be seen during blood donation and when venous blood samples are taken. However, due to skin pigments, blood vessel coverings, and an optical effect caused by the way in which light penetrates through the skin, veins typically appear blue in color.
The blood of horseshoe crabs is blue, which is a result of its high content of copper-based hemocyanin instead of the iron-based hemoglobin. Members of the lizard-family, called skinks, which belong to the genus Prasinohaema, have green blood due to a buildup of the waste product biliverdin.
Other functions
In addition to the roles in respiration, transport, immunology, and blood clotting described above, blood's additional functions may include:
- Thermoregulation: Blood circulation transports heat through the body, and adjustments to this flow are an important part of thermoregulation. Increasing blood flow to the surface (e.g., during warm weather or strenuous exercise) causes warmer skin, resulting in faster heat loss, while decreasing blood flow to the surface conserves heat.
- Hydraulic function: The restriction of blood flow can also be used in specialized tissues (such as the mammalian penis, clitoris, or nipple) to cause engorgement resulting in an erection of that tissue. Another example of blood's hydraulic function is found in the jumping spider, in which blood forced into the legs under pressure causes them to straighten for a powerful jump.
Properties and functions of blood in invertebrates
In insects, the blood (more properly called hemolymph) is not involved in the transport of oxygen. (Openings called tracheae allow oxygen from the air to diffuse directly to the tissues.) Insect hemolymph moves nutrients to the tissues and removes waste products in an open system.
Other invertebrates use respiratory proteins to increase their oxygen-carrying capacity. While hemoglobin is the most common respiratory protein found in nature, hemocyanin is found in crustaceans and mollusks, giving a blue pigmentation to their blood. It is thought that tunicates (sea squirts) might use vanabins (proteins containing vanadium) for respiratory pigmentation, which can be bright green, blue, or orange in color.
In many invertebrates, oxygen-carrying proteins are freely soluble in the blood, whereas in vertebrates they are contained in specialized red blood cells, allowing for a higher concentration of respiratory pigments without increasing viscosity or damaging blood-filtering organs like the kidneys.
Giant tube worms have particularly complex hemoglobins that allow them to live in especially harsh aquatic environments. These hemoglobins carry sulfides that are normally fatal in other animals.
Physiology of blood
Production and degradation
Blood cells are produced by specialized stem cells, located in the bone marrow, through a process termed hematopoiesis. The protein components of plasma (including clotting proteins) are produced overwhelmingly in the liver, while hormones are produced by the endocrine glands. The watery fraction is regulated by the hypothalamus and maintained by the kidney and indirectly by the gut.
Blood cells are degraded by the spleen and the Kupffer cells in the liver. The liver also clears some proteins, lipids, and amino acids. The kidney actively secretes waste products into the urine. Healthy erythrocytes have a plasma half-life of 120 days before they are systematically replaced by new erythrocytes created through hematopoiesis.
Transport
The blood is circulated around the lungs and body through the pumping action of the heart. Additional return pressure may be generated by gravity and by the actions of skeletal muscles. In mammals, blood is in equilibrium with lymph, which is continuously formed from blood (by capillary ultrafiltration) and returned to the blood (via the thoracic duct). The lymphatic circulation may be thought of as the "second circulation."
Blood type
A blood type (also called a blood group) is a classification of blood based on the presence or absence of inherited antigens on the surface of red blood cells. These antigens may be proteins, carbohydrates, glycoproteins, or glycolipids, depending on the blood group system.
While antigens from the human ABO blood group system are also found in apes, such as chimpanzees, bonobos and gorillas, the structure of the blood-group antigens in other animals and bacteria is not always identical to those typically found in humans. The classification of most animal blood groups therefore uses different blood typing systems than those used for classification of human blood.
If an individual is exposed to a blood group antigen that is not recognized as part of the self, the immune system will produce antibodies that can specifically bind to that particular blood-group antigen, and an immunological memory against that antigen is formed. These antibodies can bind to antigens on the surface of transfused red blood cells (or other tissue cells), often leading to destruction of the cells by recruitment of other components of the immune system. Thus, it is vital that compatible blood is selected for transfusions, and that compatible tissue is selected for organ transplantation. Transfusion reactions involving minor antigens or weak antibodies may lead to minor problems. However, more serious incompatibilities can lead to a more vigorous immune response with massive destruction of red blood cells, low blood pressure, and even death.
Medical terms related to blood often begin with hemo- or hemato- from the Greek word for blood (haima). The study of blood, the blood-forming organs, and blood-related diseases is referred to as hematology, a branch of biology (physiology), pathology, clinical laboratory, internal medicine, and pediatrics. Hematology includes the study of the etiology, diagnosis, treatment, prognosis, and prevention of blood diseases, which affect the production of blood and its components, such as blood cells, hemoglobin, blood proteins, and the mechanism of coagulation.
The most common disorder of the blood is anemia, a deficiency of red blood cells and/or hemoglobin. This deficiency results in a reduced ability of blood to transfer oxygen to the tissues, causing tissue hypoxia. There are several types of anemia, produced by a variety of underlying causes. Since all human cells depend on oxygen for survival, varying degrees of anemia can have a wide range of clinical consequences. The three main classes of anemia include excessive blood loss, excessive blood cell destruction (hemolysis), or deficient red blood cell production (ineffective hematopoiesis). In menstruating women, dietary iron deficiency is a common cause of deficient red blood cell production.
Hemophilia is a genetic illness that causes dysfunction in one of the blood's clotting mechanisms This disorder can allow otherwise inconsequential wounds to be life-threatening, but more commonly results in hemarthrosis, or bleeding into joint spaces, which can be crippling.
Leukemia refers to a group of cancers of the blood-forming tissues; it is characterized by an abnormal proliferation of blood cells (usually leukocytes).
Blood is also an important vector of infection. HIV, the virus that causes AIDS, is transmitted through contact with blood, semen, or the bodily secretions of an infected person. Hepatitis B and C are transmitted primarily through blood contact. Malaria and trypanosomiasis are blood-borne parasitic infections.
Blood in ancient medicine
Hippocratic medicine considered blood to be one of the four humors (together with phlegm, yellow bile and black bile). As many diseases were thought to be due to an excess of blood, bloodletting and leeching were a common intervention until the nineteenth century (it is still used for some rare blood disorders). In classical Greek medicine, blood was associated with air, springtime, and with a merry and gluttonous (sanguine) personality. It was also believed to be produced exclusively by the liver.
ReferencesISBN links support NWE through referral fees
- Alberts, B. 2005. Leukocyte leocyte functions and percentage breakdown. From B. Alberts, Molecular Biology of the Cell. NCBI Bookshelf. Retrieved April 14, 2007.
- Lawlor, R. 1991. Voices Of The First Day: Awakening in the Aboriginal Dreamtime. Rochester, VT: Inner Traditions International. ISBN 0892813555.
- Martini, F. et al. 2006. Human Anatomy, 5th ed. San Francisco: Pearson. ISBN 0805372113.
- Purves, W., D. Sadava, G. Orians, and C. Heller. 2004. Life: The Science of Biology, 7th edition. Sunderland, MA: Sinauer. ISBN 0716766728.
- Shmukler, M. 2004. Density of blood. The Physics Factbook. Retrieved October 4, 2006.
External links
All links retrieved October 31, 2023.
- Blood Online, a journal published by the American Society of Hematology.
| Cardiovascular system - edit |
|---|
| Blood | Heart → Aorta → Arteries → Arterioles → Capillaries → Venules → Veins → Vena cava → Heart → Pulmonary arteries → Lungs → Pulmonary veins → Heart |
Credits
New World Encyclopedia writers and editors rewrote and completed the Wikipedia article in accordance with New World Encyclopedia standards. This article abides by terms of the Creative Commons CC-by-sa 3.0 License (CC-by-sa), which may be used and disseminated with proper attribution. Credit is due under the terms of this license that can reference both the New World Encyclopedia contributors and the selfless volunteer contributors of the Wikimedia Foundation. To cite this article click here for a list of acceptable citing formats.The history of earlier contributions by wikipedians is accessible to researchers here:
- Blood history
- Anemia history
- Leukemia history
- Hematology history
- Serum_albumin history
- Blood_type history
- Blood_type_(non-human) history
- Interstitial_fluid history
- skink history
The history of this article since it was imported to New World Encyclopedia:
Note: Some restrictions may apply to use of individual images which are separately licensed.

